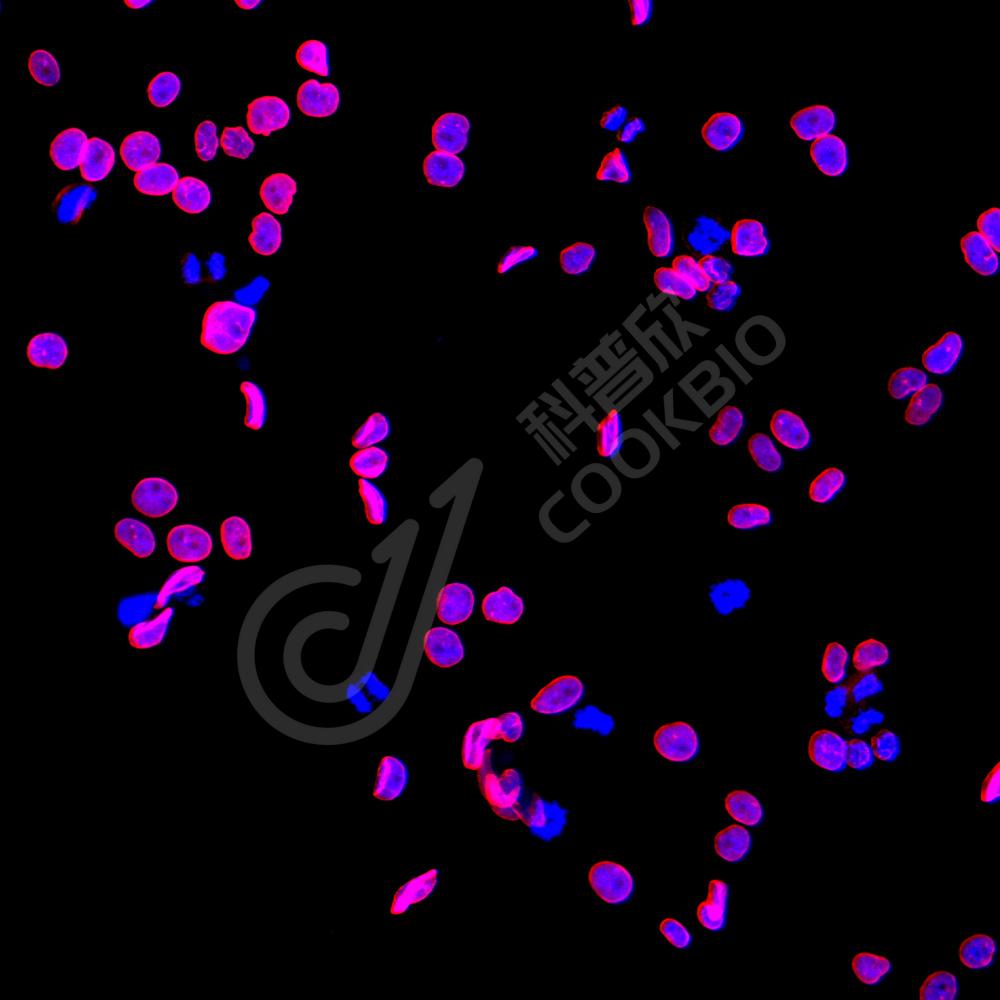

抗体筛选:
抗体筛选:
-
Anti-KPNA2 兔多克隆抗体 兔多抗原癌/抑癌基因蛋白,核受体货号:K1333888-100 规格:100 μL ¥ 1900比较查看详情
-
Anti-RANBP6 兔多克隆抗体 兔多抗核受体货号:K1335022-100 规格:100 μL ¥ 1900比较查看详情
-
Anti-Lamin B1 兔多克隆抗体 兔多抗核受体货号:K1335406-100 规格:100 μL ¥ 1900比较查看详情
-
Anti-Aly/Ref 兔多克隆抗体 兔多抗转录因子,核受体货号:K1335748-100 规格:100 μL ¥ 1900比较查看详情
-
Anti-Lamin A + Lamin C 兔多克隆抗体 兔多抗细胞器标志物,核受体货号:K1337200-100 规格:100 μL ¥ 1900比较查看详情
-
Anti-Exportin 4/XPO4 兔多克隆抗体 兔多抗核受体货号:K1337851-100 规格:100 μL ¥ 1900比较查看详情
-
Anti-NXT2 兔多克隆抗体 兔多抗核受体货号:K1337908-100 规格:100 μL ¥ 1900比较查看详情
-
Anti-NUP93 兔多克隆抗体 兔多抗核受体货号:K1337947-100 规格:100 μL ¥ 1900比较查看详情
-
Anti-NUP133 兔多克隆抗体 兔多抗核受体货号:K1338082-100 规格:100 μL ¥ 1900比较查看详情
-
Anti-NXF2 兔多克隆抗体 兔多抗核受体货号:K1338796-100 规格:100 μL ¥ 1900比较查看详情
需要技术支持?
如果您有任何问题或如果您在实验过程中遇到问题,或需要更详细的技术指导,请联系我们的技术支持团队
 400-6027-270
400-6027-270
联系我们
如果您对我们的公司或产品有任何疑问,欢迎随时联系我们

湖北省武汉市东湖新技术开发区高新二路388号生物医药加速器22栋5楼
湖北省武汉市东湖新技术开发区高新二路388号生物医药加速器22栋5楼  400-6027-270
400-6027-270  鄂公网安备42018502008544号
鄂公网安备42018502008544号